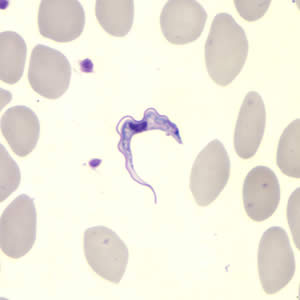

Bệnh ngủ châu Phi
Bệnh ngủ châu Phi (sleeping sickness) là một bệnh do nhiễm ký sinh trùng (KST) thuộc giống Trypanosoma, bệnh lây lan chủ yếu là do véc tơ truyền. Trypanosoma là một trùng roi ký sinh trong máu, do ruồi Glossina sp. truyền, làm tổn thương hệ thần kinh gây bệnh ngủ. Ký sinh trùng này chỉ có ở vùng nhiệt đới châu Phi, do đó, còn gọi là KST gây bệnh Trypanosoma châu Phi.
Về hình thể: ở người Trypanosoma có dạng Trypomastigote, hình thoi, dài 20μm. Dạng này sống trong máu, ngoài tế bào, có thể gặp chúng trong các hạch, trong dịch não tủy. Ở ruồi Glossina, ký chủ trung gian và trong môi trường nuôi cấy in vitro, Trypanosoma có dạng epimastigote và promastigote.

Thể trypomastigotes của Trypanosoma ssp trên lam máu nhuộm Giêmsa
Trypanosoma ssp trên lam máu giọt mỏng nhuộm Giêmsa.
(Nguồn: http://www.cdc.gov)
Dịch tễ học:
Có hai phân loài Trypanosoma gây bệnh ở người. Biểu hiện lâm sàng phụ thuộc vào loại ký sinh trùng mắc phải. Hai phân loài này phân bố ở các vùng địa lý khác nhau ở châu Phi.
Trypanosoma gambiense (T. gambiense): được tìm thấy ở 24 quốc gia vùng Tây và Trung Phi, chiếm 98% các ca bệnh ngủ được báo cáo và gây bệnh thể mạn tính. Người nhiễm KST nhưng không có dấu hiệu hoặc triệu chứng chính trong nhiều tháng thậm chí nhiều năm. Khi các triệu chứng xuất hiện rõ ràng thì bệnh đã chuyển sang giai đoạn tiến triển nặng, ảnh hưởng đến hệ thần kinh trung ương.
Trypanosoma rhodesiense (T. rhodesiense): được tìm thấy ở 13 quốc gia Đông và Nam Phi, chiếm 2% các ca bệnh ngủ được báo cáo và gây bệnh thể cấp tính. Triệu chứng đầu tiên xuất hiện sau vài tuần hoặc vài tháng sau khi nhiễm trùng. Bệnh tiến triển nhanh và xâm nhập thần kinh trung ương. Ở Uganda có cả hai loại ký sinh trùng này.
Nguồn bệnh: đối với T. gambiense, người là nguồn bệnh chính, chưa xác định rõ vai trò của động vật có vú (nuôi) và thú hoang dại. Đối với T. rhodesiense nguồn bệnh chính là động vật hoang dại và mèo nhà.
Đường lây: phần lớn là do véc tơ truyền nhưng vẫn có hình thức lây truyền khác: từ mẹ sang con, tai nạn trong phòng xét nghiệm...Nhiễm trùng do truyền máu và do quan hệ tình dục hiếm được ghi nhận. Có thể xảy ra lây truyền cơ học thông qua các loại côn trùng hút máu khác nhưng rất khó để xác định vai trò dịch tễ.
Véc tơ truyền bệnh: Ruồi Glossina sống ở khu vực nông thôn, trong rừng và trên thảo nguyên Đông Phi. Ở miền Trung và Tây Phi, chúng sống trong các khu rừng và thảm thực vật ven suối. Cả ruồi đực lẫn ruồi cái đều hút máu, hoạt động ban ngày. Một con ruồi bị nhiễm sẽ mang mầm bệnh suốt đời. Từ lúc bị nhiễm đến khi có khả năng gây bệnh cần khoảng 20 ngày. Glossina đẻ trứng và có đời sống dài từ 3 - 4 tháng.

Ruồi Glossina ssp.
(Nguồn: http://www.cdc.gov)
Bệnh xảy ra ở khu vực nông thôn, liên quan đến các nghề làm nông nghiệp, đánh cá, chăn nuôi và săn bắn.
Theo WHO, năm 1998, gần 40.000 ca bệnh đã được báo cáo nhưng ước tính đã có 300.000 trường hợp đã không được chẩn đoán và do đó không được điều trị. Dịch bệnh ngủ đã xảy ra ở các nước: Angola, Cộng hòa Dân chủ Congo và Nam Sudan. Số người chết do bệnh ngủ thậm chí còn nhiều hơn chết cho HIV/AIDS. Sau những nỗ lực phòng chống, năm 2009 - lần đầu tiên sau 50 năm, số ca bệnh trên thế giới giảm xuống dưới 10.000 (9.878) và năm 2012, đã có 7.216 ca bệnh được ghi nhận. Tuy nhiên, ước tính con số thực tế có thể lên đến 20.000 và dân số nguy cơ là khoảng 70 triệu người. Tình hình ở các nước có bệnh lưu hành: Cộng hòa dân chủ Công - gô (DRC): chiếm hơn 70 % ca bệnh được báo cáo ( trong 10 năm qua), mỗi năm có hơn 1.000 ca mắc mới và chiếm 83% số ca mắc được báo cáo năm 2012. Năm 2012, các nước Cộng hòa trung Phi, Chad và Nam Sudan báo cáo khoảng 100 - 500 ca mắc mới. Các nước như Angola, Cameroon, Congo, Ghana, Kenya, Nigeria, Uganda…báo cáo có dưới 100 ca mắc mới mỗi năm. Các quốc gia hơn 10 năm qua không có ca mắc mới nào được báo cáo: Benin, Botswana, Burkina Faso, Ethiopia, Gambia, Liberia, Senegal….dường như không còn bệnh lan truyền nhưng vẫn còn một số khu vực rất khó đánh giá chính xác tình hình bởi vì hoàn cảnh xã hội không ổn định, và/hoặc khó khăn trong hoạt động giám sát, chẩn đoán bệnh.
Chu kỳ phát triển:
Triệu chứng:
Giai đoạn đầu (giai đoạn haemolymphatic), ký sinh trùng tăng sinh ở mô dưới da, máu và bạch huyết, các dấu hiệu: sốt, nhức đầu, đau khớp và ngứa.
Giai đoạn thần kinh (giai đoạn meningoencephalic): ký sinh trùng vượt qua hàng rào máu - não để gây nhiễm cho hệ thần kinh trung ương. Ở giai đoạn này, các dấu hiệu và triệu chứng xuất hiện rõ ràng hơn: thay đổi hành vi, lú lẫn, rối loạn cảm giác và phối hợp kém. Rối loạn giấc ngủ, ban đầu là đảo lộn nhịp ngủ, sau đó ngủ mê man.
Nếu không được điều trị, bệnh nhân sẽ suy kiệt dần đến chết hoặc chết nhanh hơn do một bệnh gian phát. Nếu được điều trị trước giai đoạn thần kinh thì bệnh sẽ khỏi và không để lại di chứng, nếu điều trị muộn, khi KST đã vào hệ thần kinh trung ương thì kết quả không bảo đảm.
Chẩn đoán xác định:
Tìm KST trong máu (soi tươi hoặc sau khi nhuộm Giêmsa, hoặc sau khi làm phong phú bằng ly tâm), dịch não tủy, dịch chọc dò hạch, tủy xương (soi tươi hoặc nhuộm), cấy bệnh phẩm vào môi trường N.N.N (Nicolle, McNeal, Névy) hoặc tiêm truyền vào thú (hamster, chuột) nếu soi tươi không tìm thấy KST.
Chẩn đoán huyết thanh miễn dịch: tìm kháng thể trong máu hay trong dịch não tủy cũng có thể phát hiện được bệnh sớm và theo dõi được quá trình điều trị.
Điều trị:
Lựa chọn thuốc điều trị tùy thuộc vào loại ký sinh trùng mắc phải và giai đoạn của bệnh. Các thuốc điều trị KST ở giai đoạn đầu ít độc và dễ quản lý bệnh nhân. Phát hiện bệnh sớm thì hiệu quả điều trị sẽ tốt hơn. Ở giai đoạn hai, lựa chọn các thuốc có thể vượt qua hành rào máu - não để diệt KST, các thuốc này rất độc hại và phác đồ điều trị lâu ngày nên khó để theo dõi, quản lý bệnh nhân. Các loại thuốc được dùng để điều trị bệnh ngủ đã được WHO cấp miễn phí cho các nước có bệnh lưu hành.
Giai đoạn đầu:
• Pentamidine (1941): dùng để điều trị T. gambiense, thuốc được dung nạp tốt. Tác dụng phụ không đáng kể: hạ đường huyết, đau chỗ tiêm, tiêu chảy, nôn buồn nôn.
• Suramin (1921): dùng để điều trị T. rhodesiense, có tác dụng phụ ở đường tiết niệu và các phản ứng dị ứng, cần thử nghiệm phản ứng thuốc trước khi điều trị (liều lượng 100mg ở người lớn và 2mg đối với trẻ em).
Giai đoạn hai:
• Melarsoprol (1949): dùng để điều trị cả hai dạng KST. Thuốc có nguồn gốc từ thạch tín và có nhiều tác dụng phụ không mong muốn, nhất là hội chứng bệnh não, gây tử vong 3 - 10%. Hiện tượng KST kháng thuốc đã được phát hiện ở Trung Phi.
• Eflornithine (1990): ít độc hơn Melarsoprol, thuốc chỉ có tác dụng với T. gambiense nhưng đòi hỏi phác đồ điều trị nghiêm ngặt và khó áp dụng.
• Từ năm 2009, điều trị phối hợp giữa Eflornithine (400 mg/kg/ngày, tiêm tĩnh mạch 2 lần x 7 ngày) được kết hợp với nifurtimox uống (15 mg/kg/ngày x 10 ngày) có hiệu quả cao đối với T. gambiense.
Các biện pháp phòng chống:
Bệnh chưa có vắc xin hoặc thuốc phòng ngừa. Hai chiến lược kiểm soát bệnh ngủ chủ yếu là giảm nguồn bệnh và giảm véc tơ truyền bệnh.
Giảm nguồn bệnh ở người: phát hiện và điều trị sớm. Nhờ các phương pháp miễn dịch học để phát hiện kháng thể đặc hiệu và IgM mà công tác phát hiện bệnh được thuận lợi. Giảm nguồn bệnh là vật nuôi, thú hoang dã còn nhiều khó khăn và không hiệu quả do đi ngược lại với sự bảo vệ động vật hoang dã.
Kiểm soát véc tơ: chủ yếu là giảm thiểu tiếp xúc với ruồi Glossina. Bao gồm các biện pháp: mặc áo dài tay và quần dài, tránh lại gần các bụi cây, bẫy ruồi, dùng hóa chất diệt ruồi…
Th.S Trần Mỹ Duyên
Tài liệu tham khảo:
Lễ kỷ niệm 40 năm thành lập Viện Sốt rét – KST – CT TP. HCM (18/01/1977 – 18/01/2017) & Đón nhận Huân chương Lao động hạng I
13/01/2017Lớp tập huấn đánh giá kết quả phòng chống sốt rét giai đoạn 2011 - 2015
26/10/2015Thông báo tuyển sinh khóa 45 năm 2015
23/10/2015Công đoàn Viện Sốt rét - KST - CT TP. HCM tổ chức tham quan du lịch
19/10/2015